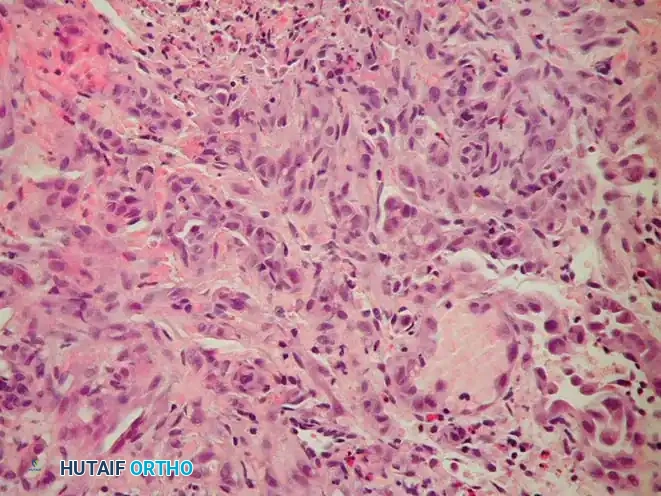
Image

Adamantinoma of Bone
Adamantinoma is a rare, low-grade primary malignant neoplasm of bone, constituting less than 1% of all primary bone malignancies. Its distinct clinicopathological features, biphasic histology, and peculiar predilection for the anterior diaphysis of the tibia make it a unique entity within orthopaedic oncology. Due to its indolent but locally aggressive nature, meticulous surgical planning and execution are paramount to prevent recurrence and preserve limb function.
Epidemiology and Etiology
Adamantinoma typically presents with a wide age distribution, but the overwhelming majority of patients are diagnosed in the second or third decade of life. While cases have been reported across all age groups, this demographic peak in young adults is notable. There is a slight male predominance, though no significant racial predilection has been established in the literature.
A hallmark feature of adamantinoma is its striking predilection for the tibia, accounting for approximately 80% to 85% of all reported cases. While other bones such as the fibula, ulna, femur, radius, and even craniofacial bones have been implicated, tibial diaphyseal involvement is overwhelmingly dominant.
The precise histogenesis remains a subject of ongoing academic debate. The prevailing hypothesis posits that adamantinoma arises from aberrant nests of epithelial cells. This theory is supported by the tumor's epithelial differentiation and its frequent occurrence in the subcutaneous location of the anterior tibia, suggesting a possible origin from displaced epidermal or adnexal epithelial rests during embryogenesis. Alternatively, it may arise from primitive mesenchymal cells possessing epithelial differentiation potential.
Clinical Pearl: Adamantinoma is widely considered to exist on a clinicopathological spectrum with Osteofibrous Dysplasia (OFD). OFD-like adamantinoma represents an intermediate lesion. The frequent co-existence of these entities necessitates extensive biopsy sampling to rule out focal areas of classic adamantinoma within a presumed OFD lesion.
Clinical Presentation
The clinical course of adamantinoma is typically insidious and protracted, reflecting its slow-growing biological behavior. Pain is the most common presenting symptom, often described as a dull, deep ache that may have been present for months or even years before the patient seeks medical attention. This prolonged symptom duration frequently leads to delayed diagnosis.
Given the tumor's common location in the subcutaneous border of the tibia, a palpable, firm mass is frequently present, particularly as the lesion expands and breaches the anterior cortex. Approximately 20% of patients present with a pathological fracture, which may be the initial catastrophic event prompting medical evaluation. Other less common symptoms include localized swelling, overlying skin changes (erythema or tethering in advanced cases), and functional impairment of the affected lower extremity.
Radiographic Features
The radiographic appearance of adamantinoma is highly characteristic, though it must be carefully differentiated from other benign and low-grade malignant bone lesions. The classic presentation on plain radiography is that of multiple, sharply demarcated radiolucent lesions within the anterior tibial diaphysis.

These lytic areas are frequently separated by regions of dense, sclerotic bone, creating a multiloculated, "bubbly," or "soap bubble" appearance. The lesion is typically eccentric, expanding the anterior cortex, and may demonstrate cortical thinning or frank destruction.
A significant portion, or even the entire length, of the tibial diaphysis can be involved. Direct extension of the tumor into the adjacent fibula is a frequent finding (occurring in up to 15% of cases), necessitating careful evaluation of both bones during initial imaging. Standard orthogonal radiographic series (anteroposterior and lateral views) covering the entire tibia and fibula are essential.
Further imaging modalities are crucial for comprehensive staging and surgical planning:
* Magnetic Resonance Imaging (MRI): The gold standard for local staging. MRI provides exquisite detail regarding the intramedullary extent of the tumor (skip lesions), cortical breach, soft tissue extension, and proximity to the anterior tibial neurovascular bundle. T1-weighted images typically show low-to-intermediate signal, while T2-weighted images demonstrate high signal intensity in the cystic/cellular areas and low signal in the fibrous/sclerotic septa.
* Computed Tomography (CT): Offers superior delineation of cortical destruction, subtle periosteal reactions, and the characteristic sclerotic changes within the bone matrix. It is particularly useful for assessing the structural integrity of the bone to predict fracture risk.
* Bone Scintigraphy (Technetium-99m): Typically demonstrates intensely increased radiotracer uptake in the affected area, indicating heightened osteoblastic activity and hyperemia.
* Positron Emission Tomography (PET-CT): Utilized primarily for systemic staging to rule out distant metastases (most commonly pulmonary), though the standardized uptake value (SUV) may be relatively low compared to high-grade sarcomas.
Pre-operative Planning and Biopsy
Thorough pre-operative planning is the cornerstone of successful oncologic surgery. An incisional or core needle biopsy is mandatory for definitive histological diagnosis prior to any definitive resection.

Surgical Warning: The biopsy tract must be meticulously planned. It should be placed longitudinally, directly over the tumor, and strictly within the planned definitive surgical incision. Transverse incisions or contamination of adjacent compartments will necessitate a much larger, potentially morbid resection later.
Image-guided core needle biopsy (as seen in the cross-sectional imaging above) allows for precise targeting of the most aggressive-appearing solid components of the tumor, avoiding purely cystic or necrotic areas that may yield non-diagnostic tissue.
Pathology
Gross Pathology
Grossly, adamantinoma typically presents as a firm, grayish-white to yellow, lobulated mass expanding within the medullary canal and cortex.

As demonstrated in the resected specimen above, areas of cystic degeneration, hemorrhage (dark red/brown areas), and necrosis are frequently interspersed with dense, fibrous tissue. The characteristic sclerotic bone separating the lytic foci can be palpated. Cortical breach and extension into the anterior compartment musculature may be evident in advanced, neglected cases.
Microscopic Pathology
Microscopically, adamantinoma is defined by its unique biphasic pattern, consisting of islands, nests, or cords of epithelial cells embedded within a prominent, bland fibrous or osteofibrous stroma.
The epithelial component, as seen in the high-power H&E stain above, can exhibit various architectural patterns, often coexisting within the same tumor:
* Basaloid: Resembling basal cell carcinoma, featuring peripheral palisading of hyperchromatic cells.
* Spindle cell: Epithelial cells adopting a spindled morphology, mimicking a low-grade sarcoma.
* Squamoid: Showing squamous differentiation, occasionally with keratin pearl formation.
* Tubular/Glandular: Forming duct-like or alveolar structures lined by cuboidal cells.
The intervening fibrous stroma often resembles fibrous dysplasia or OFD, containing bland spindle cells and trabeculae of immature woven bone rimmed by osteoblasts. Nuclear atypia in the epithelial cells is typically mild to moderate, and mitotic figures are sparse, reflecting the tumor's low-grade biological behavior.
Immunohistochemistry
Immunohistochemical profiling is absolute for confirming epithelial differentiation and distinguishing adamantinoma from purely mesenchymal spindle cell lesions.
* Positive Stains: The epithelial cells consistently express broad-spectrum cytokeratins (e.g., AE1/AE3, CK5/6, CK14, CK19) and Epithelial Membrane Antigen (EMA). Vimentin is typically co-expressed in both the epithelial and stromal components.
* Negative Stains: Markers for vascular tumors (CD31, CD34, ERG), neural tumors (S-100), and Ewing sarcoma (CD99 - though patchy positivity can rarely occur) are negative.
Differential Diagnosis
The differential diagnosis for an anterior tibial diaphyseal lesion includes:
* Osteofibrous Dysplasia (OFD): Clinically and radiographically identical in early stages. Histologically, OFD lacks the malignant epithelial nests of classic adamantinoma, though isolated cytokeratin-positive cells may be seen.
* Fibrous Dysplasia: Typically presents as a central medullary lytic lesion with a "ground-glass" matrix, lacking the aggressive cortical destruction of adamantinoma.
* Aneurysmal Bone Cyst (ABC): Expansile, multiloculated lytic lesion characterized by fluid-fluid levels on MRI.
* Metastatic Carcinoma: Must be considered in older adults. Renal cell, thyroid, and lung carcinomas can present as lytic diaphyseal lesions.
* Ewing Sarcoma: Typically occurs in a younger demographic, presenting with a highly aggressive permeative pattern, prominent periosteal reaction ("onion-skinning"), and a large soft tissue mass.
Staging and Biomechanics
Adamantinoma is staged using the Enneking Surgical Staging System for musculoskeletal tumors. Given its low-grade nature, it is typically classified as Stage IA (low grade, intracompartmental) or Stage IB (low grade, extracompartmental).
Biomechanically, the anterior tibial cortex is subjected to significant tensile forces during the gait cycle. The eccentric, lytic destruction caused by adamantinoma creates massive stress risers, severely compromising the torsional and bending strength of the tibia, hence the high rate of pathological fracture.
Surgical Management
The primary, curative treatment for adamantinoma is surgical. Due to the tumor's radioresistant and chemoresistant nature, aggressive local control via wide en bloc resection is paramount. Intralesional procedures (curettage) are strictly contraindicated and carry an unacceptably high recurrence rate (approaching 90%).
Indications for Surgery
- Histologically confirmed diagnosis of adamantinoma.
- Prevention or treatment of pathological fracture.
- Limb salvage (feasible in the vast majority of cases).
Patient Positioning and Preparation
The patient is positioned supine on a radiolucent operating table. A bump is placed under the ipsilateral hip to internally rotate the leg to a neutral position. A sterile pneumatic tourniquet is applied to the proximal thigh. The entire lower extremity, from the iliac crest to the toes, is prepped and draped free to allow for intraoperative assessment of alignment and potential autograft harvest (e.g., iliac crest or contralateral fibula).
Surgical Approach (Anteromedial Tibia)
- Incision: A longitudinal incision is made over the anteromedial aspect of the tibia, incorporating the previous biopsy tract with a 2-3 cm elliptical margin of normal skin.
- Dissection: The incision is carried down through the subcutaneous tissue. Flaps are elevated full-thickness.
- Compartment Management: The deep fascia is incised. Dissection must proceed extraperiosteally. The anterior compartment musculature (tibialis anterior) is mobilized laterally. If the tumor breaches the anterior cortex and invades the muscle, a cuff of the involved muscle must be resected en bloc with the bone.
- Neurovascular Protection: The anterior tibial artery and deep peroneal nerve are identified in the interosseous space and meticulously protected. If the tumor extends posteriorly or laterally, these structures must be carefully dissected free, provided they are not directly encased by the tumor.
Resection Technique
- Osteotomy Planning: Based on pre-operative MRI, the proximal and distal osteotomy sites are marked. A wide margin of 2 to 3 cm of normal-appearing medullary bone beyond the MRI signal abnormality is standard.
- Execution: Using an oscillating saw under continuous saline irrigation (to prevent thermal necrosis), the transverse osteotomies are performed.
- Fibular Evaluation: If the fibula is involved, a concomitant segmental fibulectomy is performed en bloc with the tibial segment.
- Margin Assessment: Intraoperative frozen sections of the medullary canal contents at the proximal and distal osteotomy sites are sent to pathology to confirm negative margins before proceeding with reconstruction.
Reconstruction Strategies
Reconstructing a massive intercalary diaphyseal defect of the tibia is a formidable orthopaedic challenge. The goal is to provide immediate structural stability and long-term biological durability.
- Intercalary Structural Allograft: A size-matched cadaveric diaphyseal allograft is utilized. It is fixed using a long, heavy-duty locking compression plate spanning the entire tibia. While providing immediate stability, allografts carry risks of non-union at the host-graft junction, late fracture, and deep infection.
- Vascularized Free Fibula (VFF) Autograft: Harvesting the contralateral fibula with its vascular pedicle (peroneal artery/vein) and anastomosing it to the recipient site vessels provides living bone that hypertrophies over time.
- The Capanna Technique: A highly effective hybrid approach combining a massive structural allograft (for immediate mechanical strength) with an intramedullary vascularized free fibula (for biological osteogenesis and revascularization of the allograft).
- Bone Transport (Ilizarov Method): Utilizing a circular external fixator to perform a corticotomy and gradually transport a segment of healthy bone across the defect (distraction osteogenesis). This is highly biological but requires prolonged external fixation and intensive patient compliance.
Postoperative Care and Rehabilitation
- Immobilization: Postoperatively, the limb is placed in a well-padded posterior splint or cast.
- Weight-Bearing: Strict non-weight-bearing is enforced for 6 to 12 weeks, depending on the reconstruction method. VFF and allograft reconstructions require prolonged protection until radiographic evidence of host-graft union is observed.
- DVT Prophylaxis: Chemical and mechanical deep vein thrombosis prophylaxis is mandatory.
- Rehabilitation: Early mobilization of the knee and ankle joints (if not spanned by the fixation) is encouraged to prevent stiffness. Progressive weight-bearing is initiated only after definitive signs of bony union.
Prognosis and Follow-up
Adamantinoma has an excellent overall survival rate (exceeding 85% at 10 years) if treated with appropriate wide resection. However, it possesses a notorious potential for late local recurrence and distant metastasis (primarily to the lungs and regional lymph nodes).
Clinical Pearl: The indolent nature of adamantinoma means recurrences can occur 10, 15, or even 20 years post-resection. Lifelong, diligent oncologic surveillance is mandatory.
Follow-up protocols include physical examination and plain radiographs of the reconstructed limb every 3 months for the first 2 years, every 6 months up to 5 years, and annually thereafter. Chest CT should be performed at similar intervals to screen for pulmonary micrometastases.
Malignant Vascular Tumors of Bone
Malignant vascular tumors of bone represent a highly heterogeneous and exceedingly rare group of primary bone sarcomas characterized by neoplastic endothelial cell differentiation. Historically, the nomenclature surrounding these lesions has been convoluted, leading to diagnostic and therapeutic challenges.
Terminology and Classification
Modern orthopaedic oncology classifies these tumors based on their histological grade and biological aggressiveness:
* Epithelioid Hemangioendothelioma (EHE): Represents the low-to-intermediate grade spectrum. These tumors exhibit distinct vascular differentiation but are composed of epithelioid-appearing endothelial cells with intracytoplasmic vacuoles (representing primitive vascular lumens). They possess an unpredictable clinical course, capable of both indolent local growth and sudden metastatic spread.
* Angiosarcoma (High-Grade Hemangiosarcoma): Represents the highly aggressive, high-grade end of the spectrum. These are poorly differentiated neoplasms characterized by marked cellular pleomorphism, high mitotic indices, extensive necrosis, and rapid, destructive local growth with early hematogenous metastasis.
Collectively, malignant vascular tumors account for less than 1% of all primary bone sarcomas.
Epidemiology and Etiology
These tumors can occur at any age, though they most frequently present in the third to fifth decades of life. There is a slight male predilection. Unlike adamantinoma, vascular tumors can arise in virtually any bone, with the long bones of the lower extremity (femur, tibia), the pelvis, and the axial skeleton being the most common sites.
A unique and defining characteristic of vascular bone tumors is their propensity for multicentricity. Up to 30% of patients will present with multiple lesions within the same bone, the same extremity, or widely disseminated throughout the skeleton.
Clinical and Radiographic Presentation
Patients typically present with localized, progressively worsening pain and swelling. In high-grade angiosarcomas, the clinical progression is rapid, and pathological fractures are common due to aggressive osteolysis.
Radiographically, vascular tumors present as purely lytic, destructive lesions.
* Low-grade lesions (EHE): May show a "soap bubble" appearance with some reactive sclerosis at the margins, occasionally mimicking adamantinoma or fibrous dysplasia.
* High-grade Angiosarcoma: Demonstrates a highly aggressive, permeative pattern of bone destruction with ill-defined, "moth-eaten" margins, cortical breakthrough, and a lack of periosteal reaction.
MRI is critical for defining the extent of marrow replacement and soft tissue invasion. Whole-body MRI or PET-CT is absolutely essential during initial staging to identify multicentric disease, which drastically alters the treatment paradigm.
Pathology
Histological diagnosis requires a high index of suspicion and expert musculoskeletal pathology review.
* EHE: Characterized by cords or nests of plump, epithelioid endothelial cells set within a myxohyaline stroma. The hallmark feature is the presence of intracellular vacuoles containing red blood cells ("blister cells").
* Angiosarcoma: Shows chaotic, anastomosing vascular channels lined by highly atypical, hyperchromatic endothelial cells. Solid sheets of anaplastic cells with frequent mitoses and necrosis are common.
Immunohistochemistry is definitive. Both EHE and angiosarcoma will strongly express endothelial markers, specifically CD31, CD34, ERG, and Factor VIII-related antigen. EHE may also aberrantly express cytokeratins, which can lead to a misdiagnosis of metastatic carcinoma if a full panel is not utilized.
Surgical and Oncological Management
The management of malignant vascular tumors is highly individualized, dictated by the tumor grade and the presence of multicentricity.
Localized Disease
For solitary lesions (both EHE and localized angiosarcoma), the gold standard is wide en bloc surgical resection with negative margins, followed by complex limb reconstruction as detailed in the adamantinoma section.
Multicentric and Metastatic Disease
The presence of multicentric disease complicates surgical management.
* If multicentric lesions are confined to a single limb (e.g., multiple lesions in the femur and tibia), radical resection or amputation (e.g., hip disarticulation) may be required to achieve local control.
* For widely disseminated disease, surgery is relegated to palliation (e.g., prophylactic intramedullary nailing of impending pathological fractures).
Adjuvant Therapies
- Radiation Therapy: Angiosarcomas are generally considered moderately radiosensitive. Adjuvant radiotherapy is frequently employed following wide resection, particularly if surgical margins are close or positive, or as primary palliative treatment for unresectable lesions.
- Chemotherapy: The role of systemic chemotherapy remains controversial due to the rarity of the disease. However, for high-grade angiosarcomas, multi-agent neoadjuvant or adjuvant chemotherapy (often utilizing doxorubicin and paclitaxel-based regimens) is frequently administered in an attempt to control micrometastatic disease, though overall survival remains poor.
In conclusion, both adamantinoma and malignant vascular tumors of bone require a multidisciplinary approach involving orthopaedic oncologists, musculoskeletal radiologists, and pathologists. Meticulous surgical execution, prioritizing wide oncologic margins and durable biological reconstruction, remains the cornerstone of maximizing patient survival and functional outcomes.
📚 Medical References
- adamantinoma of long bones: an international study, J Bone Joint Surg 82A:1122, 2000.
- Radley TJ, Liebig CA, Brown JR: Resection of the body of the pubic bone, the superior and inferior pubic rami, the inferior ischial ramus, and the ischial tuberosity: a surgical approach, J Bone Joint Surg 36A:855, 1954.
- Ramappa AJ, Lee FY, Tang P, et al: Chondroblastoma of bone, J Bone Joint Surg 82A:1140, 2000.
- Randall R, Bruckner J, Lloyd C, et al: Sacral resection and reconstruction for tumors and tumor-like conditions, Orthopedics 28:307, 2005.
- Rao BN, Champion JE, Pratt CB, et al: Limb salvage procedures for children with osteosarcoma: an alternative to amputation, J Pediatr Surg 18:901, 1983.
- Renard A, Veth R, Schreuder H, et al: The saddle prosthesis in pelvic primary and secondary musculoskeletal tumors: functional results at several postoperative intervals, Arch Orthop Trauma Surg 120:188, 2000.
- Renard AJ, Veth RP, Schreuder HWB, et al: Function and complications after ablative and limb-salvage therapy in lower extremity sarcoma of bone, J Surg Oncol 73:198, 2000.
- Richardson MJ, Dickinson IC: Giant cell tumor of bone, Bull Hosp Jt Dis 57:6, 1998.
- Riebel G, Webster DA: Proximal humeral replacement for tumor: a preliminary report, Orthopedics 12:833, 1989.
- Riley LH III, Frassica DA, Kostuik JP, et al: Metastatic disease to the spine: diagnosis and treatment, Instr Course Lect 49:471, 2000.
- Roberts P, Chan D, Grimer RJ, et al: Prosthetic replacement of the distal femur for primary bone tumours, J Bone Joint Surg 73B:762, 1991.
- Rodgers WB, Mankin HJ: Metastatic malignant chondroblastoma, Am J Orthop 25:846, 1996.
- Rodriguez-Galindo C, Billups C, Kun L, et al: Survival after recurrence of Ewing tumors: the St. Jude Children’s Research Hospital experience, 1979–1999, Cancer 94:561, 2002.
- Rompen JC, Ham SJ, Halbertsma JP, et al: Gait and function in patients with a femoral endoprosthesis after tumor resection: 18 patients evaluated 12 years after surgery, Acta Orthop Scand 73:439, 2002.
- Roscoe MW, McBroom RJ, St Louis E, et al: Preoperative embolization in the treatment of osseous metastases from renal cell carcinoma, Clin Orthop Relat Res 238:302, 1989.
- Rosen G, Loren GJ, Brien EW, et al: Serial thallium-201 scintigraphy in osteosarcoma: correlation with tumor necrosis after preoperative chemotherapy, Clin Orthop Relat Res 293:302, 1993.
- Rosito P, Manchini AF, Rondelli R, et al: Italian cooperative study for the treatment of children and young adults with localized Ewing sarcoma of bone: a preliminary report of 6 years of experience, Cancer 86:421, 1999.
- Ross AC, Sneath RS, Scales JT: Endoprosthetic replacement of the humerus and elbow joint, J Bone Joint Surg 69B:652, 1987.
- Rougraff B: Indications for operative treatment, Orthop Clin North Am 31:567, 2000.
- Rougraff BT, Kneisl JS, Simon MA: Skeletal metastases of unknown origin: a prospective study of a diagnostic strategy, J Bone Joint Surg 75A:1276, 1993.
- Rougraff BT, Simon MA, Kneisl JS, et al: Limb salvage compared with amputation for osteosarcoma of the distal end of the femur: a long-term oncological, functional, and qualityof-life study, J Bone Joint Surg 76A:649, 1994.
- Rubert CK, Malawer MM, Rosenthal JL: Reconstruction with the saddle prosthesis: indications, surgical technique, and results, Semin Arthroplasty 10:171, 1999.
- Ruggieri P, Capanna R, Biagini R, et al: Resection of the distal tibia in bone tumors, Ital J Orthop Traumatol 13:299, 1987.
- Ruggieri P, McLeod RA, Unni KK, et al: Mayo Clinic tumor rounds: osteoblastoma, Orthopedics 19:621, 1996.
- Rutten MJ, Schreurs BW, van Kampen A, et al: Excisional biopsy of impalpable soft tissue tumors: US-guided preoperative localization in 12 cases, Acta Orthop Scand 68:384, 1997.
- Rydholm A: Reconstruction after resection of the proximal ulna: report of a case of chondrosarcoma, Acta Orthop Scand 58:671, 1987.
- Rydholm A, Akerman M, Idvall I, et al: Aspiration cytology of soft tissue tumours: a prospective study of its infl uence on choice of surgical procedure, Int Orthop 6:209, 1982.
- Safran MR, Kody MH, Namba RS, et al: 151 endoprosthetic reconstructions for patients with primary tumors involving bone, Contemp Orthop 29:15, 1994.
- Saglik Y, Yildiz Y, Karakas A, et al: Giant cell tumor of bone, Bull Hosp Jt Dis 58:98, 1999.
- Sahu K, Pai RR, Khadilkar UN: Fine needle aspiration cytology of the Ewing’s sarcoma family of tumors, Acta Cytol 44:332, 2000.
- Saifuddin A, Mitchell R, Burnett SJD, et al: Ultrasound-guided needle biopsy of primary bone tumours, J Bone Joint Surg 82B:50, 2000.
- Saifuddin A, Sherazi Z, Shaikah MI, et al: Spinal osteoblastoma: relationship between paravertebral muscle abnormalities and scoliosis, Skeletal Radiol 25:531, 1996.
- Saifuddin A, White J, Sherazi Z, et al: Osteoid osteoma and osteoblastoma of the spine: factors associated with the presence of scoliosis, Spine 23:47, 1998.
- Sajadi KR, Heck RK, Neel MD, Rao BN, et al: The incidence and prognosis of osteosarcoma skip metastases, Clin Orthop Relat Res 426:92, 2004.
- Sakkers RJB, Van Der Heul RO, Kroon HM, et al: Late malignant transformation of a benign giant-cell tumor of bone: a case report, J Bone Joint Surg 79A:259, 1997.
- Salmon JM, Kilpatrick SE: Pathology of skeletal metastases, Orthop Clin North Am 31:537, 2000.
- San Julian Aranguren M, Leyes M, Mora G, et al: Consolidation of massive bone allografts in limb-preserving operations for bone tumours, Int Orthop 19:377, 1995.
- Sanjay BKS, Frassica FJ, Frassica DA, et al: Treatment of giantcell tumor of the pelvis, J Bone Joint Surg 75A:1466, 1993.
- Sar C, Eralp L: Surgical treatment of primary tumors of the sacrum, Arch Orthop Trauma Surg 122:148, 2002.
- Sasaki T, Yagi T: Computerized axial tomography (CAT): the value in the diagnosis of bone and soft tissue tumours, Ital J Orthop Traumatol 8:93, 1982.
- Satcher RL, O’Donnell RJ, Johnston JO: Reconstruction of the pelvis after resection of tumors about the acetabulum, Clin Orthop Relat Res 409:209, 2003.
- Scarborough MT: Allograft-allograft healing? Salvage of massive allografts after fracture, Clin Orthop Relat Res 382:28, 2001.
- Scarborough MT, Moreau G: Benign cartilage tumors, Orthop Clin North Am 27:583, 1996.
- Schirrmeister H, Guhlmann A, Kotzerke J, et al: Early detection and accurate description of extent of metastatic bone disease in breast cancer with fl uoride ion and positron emission tomography, J Clin Oncol 17:2381, 1999.
- Schneider R: Percutaneous needle bone biopsy, Orthop Rev 12:119, 1983.
- Schurmann M, Gradl G, Andress HJ: Metastatic lesions of the humerus treated with the isoelastic diaphysis prosthesis, Clin Orthop Relat Res 380:204, 2000.
- Schwameis E, Dominkus M, Krepler P, et al: Reconstruction of the pelvis after tumor resection in children and adolescents, Clin Orthop Relat Res 402:220, 2002.
- Schwartz HS, Frassica FJ, Sim FH: Rotationplasty: an option for limb salvage in childhood osteosarcoma, Orthopedics 12:257, 1989.
- Scully SP, Ghert MA, Zurakowski D, et al: Pathologic fracture in osteosarcoma: prognostic importance and treatment implications, J Bone Joint Surg 84A:49, 2002.
- Scully SP, Ghert MA, Zurakowski D, et al: Pathologic fracture in osteosarcoma: prognostic importance and treatment implications, J Bone Joint Surg 84A:49, 2002.
- Scully SP, Mott MP, Temple HT, et al: Late recurrence of giantcell tumor of bone: a report of four cases, J Bone Joint Surg 76A:1231, 1994.
- Scully SP, Temple HT, O’Keefe RJ, et al: The surgical treatment of patients with osteosarcoma who sustain a pathologic fracture, Clin Orthop Relat Res 324:227, 1996.
- Sessa S, Sommelet D, Lascombes P, et al: Treatment of Langerhans-cell histiocytosis in children: experience at the children’s hospital of Nancy, J Bone Joint Surg 76A:1513, 1994.
- Shea KG, Coleman DA, Scott SM, et al: Microvascularized free fi bular grafts for reconstruction of skeletal defects after tumor resection, J Pediatr Orthop 17:424, 1997.
- Shih HN, Hsu RWW, Sim FH: Excision curettage and allografting of giant cell tumor, World J Surg 22:432, 1998.
- Shikata J, Yamamuro T, Shimizu K, et al: Surgical treatment of giant-cell tumors of the spine, Clin Orthop Relat Res 278:29, 1992.
- Shin KH, Rougraff BT, Simon MA: Oncologic outcomes of primary bone sarcomas of the pelvis, Clin Orthop Relat Res 304:207, 1994.
- Shives TC: Biopsy of soft-tissue tumors, Clin Orthop Relat Res 289:32, 1993.
- Siegel RD, Ryan LM, Antman KH: Osteosarcoma in adults: one institution’s experience, Clin Orthop Relat Res 240:261, 1989.
- Sim FH, Beauchamp CP, Chao EYS: Reconstruction of musculoskeletal defects about the knee for tumor, Clin Orthop Relat Res 221:188, 1987.
- Sim FH, Edmonson JH, Wold LE: Soft tissue sarcomas: future perspectives, Clin Orthop Relat Res 289:1062, 1993.
- Simon MA: Current concepts review: causes of increased survival of patients with osteosarcoma: current controversies, J Bone Joint Surg 66A:306, 1984.
- Simon MA: Current concepts review: limb salvage for osteosarcoma, J Bone Joint Surg 70A:307, 1988.
- Simon MA, Finn HA: Diagnostic strategy for bone and soft tissue tumors, J Bone Joint Surg 75A:622, 1993.
- Simon MA, Kirchner PT: Scintigraphic evaluation of primary bone tumors: comparison of technetium-99m phosphonate and gallium citrate imaging, J Bone Joint Surg 62A:758, 1980.
- Simon MA, Springfi eld D, eds: Surgery for bone and soft-tissue tumors, Philadelphia, 1998, Lippincott-Raven. Simpson AHRW, Porter A, Davis A, et al: Cephalad sacral resection with a combined extended ilioinguinal and posterior approach, J Bone Joint Surg 77A:405, 1995.
- Skarin A, ed: Diagnosis in oncology: lung cancer presenting with solitary bone metastases, J Clin Oncol 17:2995, 1999.
- Smith DG, Behr JT, Hall RF, et al: Closed fl exible intramedullary biopsy of
